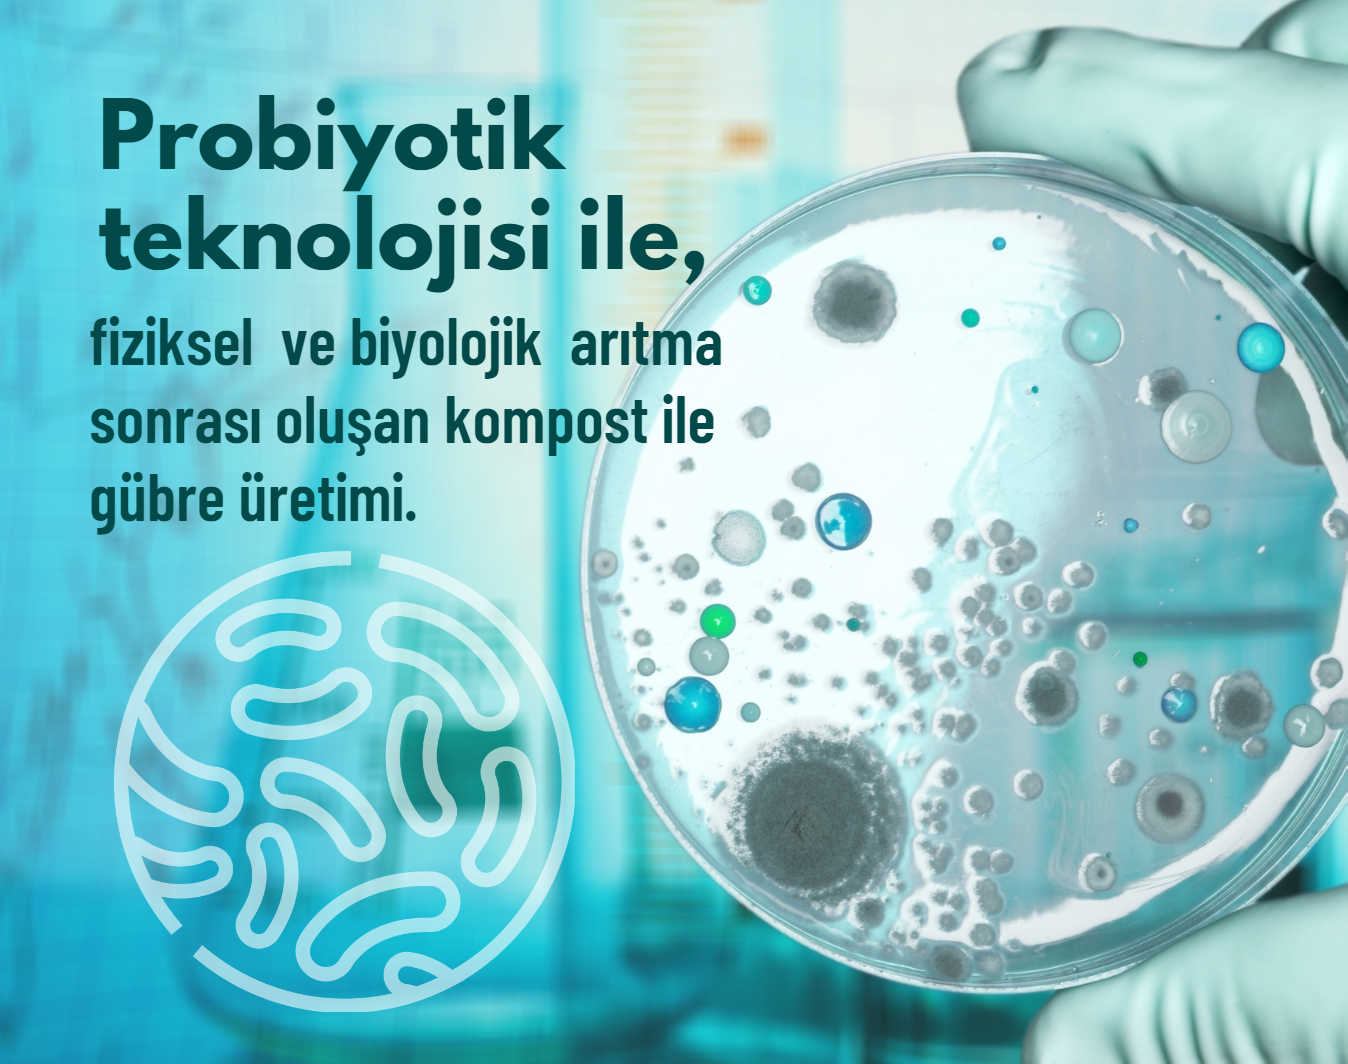

AMASYA TERS AKAN PROJESİ
AMASYA TERS AKAN PROJESİ

DEĞERLENDİRME
Su Analizinde bakılan değerler doğrultusunda;
Askıda Katı Madde,
Toplam Çözünmüş Madde
Toplam Fosfor,
Biyolojik Oksijen Miktarı,
Kimyasal Oksijen Miktarı,
Toplam Azot,
azalmakla birlikte; Çözünmüş Oksijen Miktarında artış gözlenmiştir.



Tersakan Çayı, Ladik Gölü'nden doğan, 100 km uzunluğundaki akarsu. Yeşilırmak'ın sol kollarından biridir. Uzunluğu 91,4 km, su toplama havzası 2684 km²'dir. Çay, Ladik Gölü'nden çıktıktan sonra önce batıya, sonra güneye, sonra da doğuya doğru akarak Yeşilırmak ile birleşir.
PROBİYOTİK TEKNOLOJİSİ
Amasya Belediyesi iş birliği ile gerçekleştirilen çalışmalarında; tersakan akarsuyundan alınan numuneler Amasya ve 19 Mayıs üniversiteleri laboratuvarlarında analiz edilmiştir. Uygulama öncesi analizleri yapılan numunelere, Amasya Üniversitesi tarafından onaylanan probiyotik özelliği olduğu bilinen 5 Bacillus cinsi bakteri ile probiyotik uygulaması gerçekleştirilmiştir.
GÜNCEL DURUM
Tersakan Çayı, yıllardır hayvan çiftlikleri, organize sanayi bölgesi ve kömür işletmesinin atıklarıyla kirleniyor. Simsiyah akan Tersakan Çayı, Yeşilırmak Nehri'ni de kirletmektedir.
Zamanla oluşan kirlilik, kötü koku oluşumuna ve çay üzerinde köpüklerin oluşmasına sebep olmaya başlamıştır.




BUTAL UYGULAMA ÖNCESİ ANALİZ RAPORU
08 Kasım 2023 Tarihinde BUTAL tarafından tersakandan alınan su örneğimizin Probiyotik Uygulaması öncesi su analizleri yapılmıştır.

BUTAL UYGULAMA SONRASI ANALİZ RAPORU
13 Kasım 2023 Tarihinde, yine BUTAL tarafından önceki analizi gerçekleştirilen su örneğine Probiyotik Uygulaması yapıldıktan 3 gün sonra tekrar su analizi yapılmıştır.